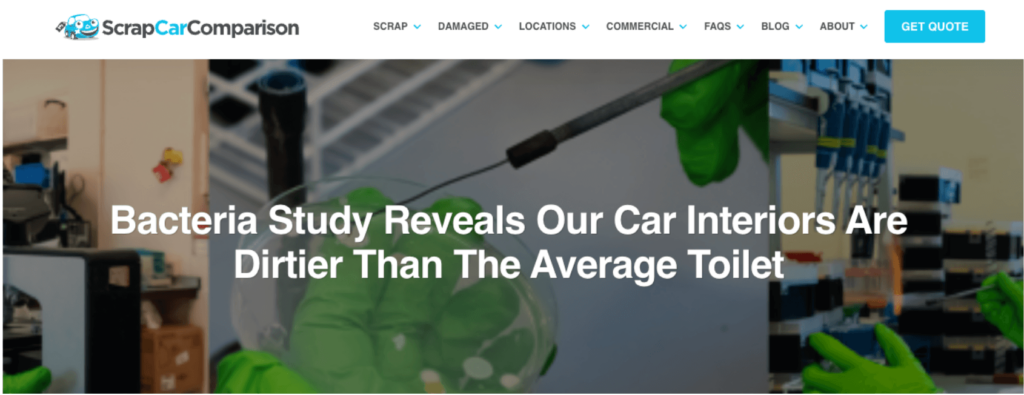
scrap car post

Table of Contents
- High-authority, relevant backlinks from digital PR campaigns strongly correlate with improved keyword rankings.
- Google’s leaked documents confirm link quality, internal linking, and freshness influence SEO performance.
- Campaigns using proprietary data or unique angles boost chances of AI citations and evergreen traffic.
- “Best cities,” statistics, and data-driven posts drive consistent backlinks and organic growth when optimized.
- Digital PR impacts rankings directly (linked content) and indirectly (internal links to money pages).
- For SEO gains, pitch to relevant, frequently updated sites that offer followed links and include brand keywords.
The term digital PR may differ slightly depending on who you ask.
We recently discussed the differences between US and UK digital PR with Rise at Seven’s Will Hobson on our podcast.
But ultimately, the goal is the same: to get high-authority links to boost rankings and brand awareness.
As digital PR continues to grow and refine worldwide, with new agencies and sites adopting the strategy daily, we thought it was worth exploring how brands use digital PR to support their SEO goals.
No two brands are the same, but there are some key strategies that you can use in digital PR to help support SEO.
How Does Digital PR Help SEO?
In short, studies show that getting high-authority links can improve rankings.
Most wield digital PR by getting links to a page directly and then internally linking to a secondary page that they want to get ranking.
Link building does not happen in a vacuum. We’ve all but confirmed that other factors, like clicks, may also impact rankings.
So, first, I’ll show you some studies showing a strong correlation between ranking and links. Later in this post, I’ll show you significant evidence of organic traffic boosts from digital PR to individual pages.
Last, I’ll discuss directional digital pr metrics.
Links Impact Site Authority
Several flagship studies have shown a correlation between overall site authority metrics and backlinks.
One study from Backlinko analyzed over 1.18 million keywords and the top ten ranking URLs for each to identify correlations.
They found that the top-ranking result in Google has almost four times more backlinks than positions 2-10.

Another point found that Ahrefs Domain Rating correlates with higher rankings.

SEMRush’s Ranking Factors Study analyzed over 16,000 keywords and analyzed the top 20 positions and their performance.
As you can see in the image below, several backlink factors (in yellow), including domain authority, number of referring domains, and number of backlinks, are highly correlated with ranking.

A study by Feed the Bot found that 96.3% of the top 10 sites have over 1,000 unique domain backlinks.

However, not all links are equal. In our post about the number of backlinks you need, I showed how looking at the raw quantity of links is misleading.
Sites need quality, relevant backlinks to improve their domain’s authority and rank for keywords.
Another Moz study reached similar conclusions. In 2021, it examined the first 20 organic results for every MozCast keyword (10,000 keywords).

They, too, found that the number of links to a page was highly correlated with ranking.

They also found that Page Authority was highly correlated with ranking, meaning that links from authoritative sources play a bigger role.
After the 2024 Google leak, even more potential connections between ranking and links have come to light.
What the Google Leak Says
Many SEOs have found connections between links and ranking based on the leaked documentation from Google.
The documentation mentions a locality and bucket when referencing links and ranking:

A link’s quality is categorized as low, medium, and high:

Many believe this supports Google’s use of a link’s relevancy and quality for ranking purposes.
The documentation even supports evidence that Google can track links across pages even when not directly linked.

This supports the common digital PR practice of getting links to a page and then passing that link value internally via an internal link to a product or service page. (More on that later.)
There’s a lot of evidence to support how high-authority, relevant links can impact rankings. But let’s look deeper at where Google is headed with AI and LLMs.
AI Wants Unique Information
Google wants things they haven’t seen before.
After the Helpful Content Update, many sites were penalized for simply regurgitating the same information as everyone else. (Though Google does seem to show bias to news sites—more on this later.)
One of the central tenets of their self-assessment has been to provide “original information, reporting, research, or analysis,” as seen below.

But the future brings even more adjustments to Google, including AI.
LLMs Need Fresh Information
Campaigns that provide unique data are primed to succeed during AI.
Large Language Models (LLMs) like ChatGPT and Google’s AI Overviews need fresh information and data. When they cite information, you can be cited within that.
Check out the example below of how ZipRecruiter is getting mentioned in the AI Overview and then cited as a source below:

So, by providing unique data in your content, you put yourself in the best position to rank and get links and exposure over time.
But Are Links the Cause of the Rankings or the Result?
In some cases, they can go hand-in-hand. In the next section of this post, I will show you how many brands use content to build links and organic traffic over time.
Some might argue that you build links because a post is ranking, not vice versa.
This can be the case sometimes.
A well-known brand like Nike may not need to manually build links to help their pages rank because they naturally get mentioned in the press.
Some keywords have high link intent and are often searched for and cited within blog posts or news articles.
Sites focusing on these high-link intent keywords can gain more links over time (as we’ll see next.)
Let’s look at how to run a digital PR campaign that ticks SEO boxes.
Using Digital PR to Increase Rankings
In all cases, finding that happy ground between keyword-driven content and pitchable digital PR content is where you can make the most significant impact.
You can drive relevant organic traffic and bring in high-quality, relevant links.
The challenge is always how to make keyword-driven content link-worthy.
The answer is with unique content.
So, let’s look at some examples of how brands do this to improve their SEO.
Best Cities for X
In a “best cities” or “index” campaign, the goal is to create a ranking of cities, states, or countries, rank them, and then pitch the winners (or losers) to those regional news publications.
Most start by identifying keywords that are relevant to their industry. For instance, here is a snapshot of keywords with “best cities for”:

The question to ask is, can this get me relevant links? Can this get me coverage from a place that makes sense and supports my statements?
For example, when creating digital PR for a construction rental company, I knew I wanted to focus on construction industry publications.
However, it might not be that obvious. Sometimes, you must leave your primary service offering area to get links.
For example, WalletHub is a personal finance publication. They rank for hundreds of “best cities for X” queries tangentially related to personal finance.
Take a look at this snapshot from Ahrefs Site Explorer:

Digging into the backlink profiles for these posts, you’ll see a steady stream of backlinks and increasing organic traffic over time.
You can also see short surges of traffic right when the post is published, pitched, and subsequently updated and repitched.
For example, here are the best cities for families:

But, to make this work, you don’t have to be a high-authority site like WalletHub.
Here is a DR 63 site that did a post about the best cities for runners:

Here is a DR 42 site that looked at the best cities for biking:

Again, you can see the impact of the digital PR campaign on organic traffic at publishing and right at the time of the update.
One thing you may notice is that the traffic is waning between updates. This is due to a few factors, but “best cities” don’t always have much interest year-round. And if sites aren’t getting clicks or searches, the traffic can drop.
So, let’s look at a keyword type that can get more consistent traffic: statistics.
Statistics Posts
Statistics posts are any kind of post that rounds up relevant statistics about a current subject and presents them in a digestible, easily citable way in a post.
The way these work for digital PR and SEO is that they have both search volume and high link intent, meaning they are topics often searched for and cited.
For instance, here is the link profile for a customer service statistics post. You can see that it slowly gains links over time.

However, to truly make this digital PR, you must pitch them first. And to make something pitchable, you need to give something of value.
Value can be something like a pitchable asset, such as this construction statistics post, which includes an infographic that can be pitched for coverage:

But another way to create value is by using proprietary data for your statistics posts.
This is data that no one else has and can be extremely valuable when pitched correctly. (Check out how to pitch media.)
Hubspot’s Marketing Statistics report is an excellent example of this.
They survey and publish their data results each year. As you can see, their links grow along with the organic traffic (although it dips a bit yearly, it’s not nearly as drastic as the city studies mentioned above).

They rank for “marketing statistics” and get links over time.
However, statistics keywords aren’t the only ones with high link intent. Other general data queries can bring in passive links while still being pitchable.
Let’s look at these next.
Data-related queries
General data-related queries can also have high link intent. If you can make these pitchable, you can see gains across organic and links.
This study from Attentive is based on proprietary survey data, giving them something unique to pitch, while being also setting themselves up to rank.

It ranks for “millennial shopping habits,” which gives it high link intent but also a monthly search volume of 80.
Looking at the overview in Ahrefs, you can already see the traffic and link gains moving together.

Here’s another piece by Insurify that looks at the most ticketed cars. They used their proprietary data from thousands of insurance claims to determine the car models that get the most speeding tickets.
Then, they pitched it for coverage.

This piece ranks for “most ticketed cars in america”, which gets 250 searches per month, and has accrued over 400 links.
You also see a boost in links and rankings when they published and refreshed.

(There is slightly more than meets the eye to this post as it was updated after Insurify’s merger with Compare, which is most likely why you see that big boost with the publish date.)
But let’s look outside the data-related queries and into my favorite (and most underutilized) way to tie digital PR to SEO: informational queries. That’s up next.
Informational Queries
You can also get creative with how you tie digital PR campaigns to keywords.
If you can take any old question and provide proprietary data to make your content pitchable, you are uniquely set up to rank for the keyword and grow links over time.
Casper took the informational query “couples’ sleeping positions,” which gets 800 monthly searches, and made it pitchable by gathering their proprietary data.
They answered the query in the post by listing the different sleeping positions and what they meant, but then they supplemented the post with survey data to pitch to journalists.

You can see from the results that the piece gains organic traffic and links over time.

In all of these cases, digital PR directly impacts organic traffic.
Next, we’ll examine how brands use digital PR to build domain authority.
Using Digital PR to Increase Rankings Indirectly
Building links to a product page or money page can be challenging. So, the common practice is to create links to related content and then internally link to a money page or home page.
Most digital PR campaigns use the indirect approach to supporting rankings.
Because of this indirect relationship, you are more likely to find directional data supporting the campaigns.
Here are some signals you can look at with this tactic:
Money Page Traffic Increase
With this tactic, you can pass some of that link value to help your money page rank specifically.
I say “some” of that value because it is unclear how much passes through via an internal link. (It is safe to say that if it were 100%, then we’d see everyone’s money pages ranking all over the place.)
But if you remember this graphic from earlier, it is clear Google may track this kind of internal linking:

So, this is what we mean when discussing using digital PR to help SEO indirectly. You both boost the overall site domain authority, making it easier to rank overall, and you boost a specific page through internal linking.
The digital PR campaign below by ScrapCarComparison looked at how dirty car interiors are.
They got over 190 referring domains, and while it doesn’t rank for a keyword, you can see that they link to one of their money pages at the top of the piece.

This way, all the link value gained can be funneled to their money page. Then, if we look at the money page itself (which is a page about scrapping cars), we can perhaps see a brief boost.

You can also look at homepage traffic increases. Let’s look at this next.
Homepage Traffic Increase
One of my favorite posts of all time is from Signs.com. They asked users to try to draw common logos from memory and plotted them on a graphic based on their proximity to the actual logo.

This has drawn over 500 referring domains over time.
And when you look at the impact, there is a boost in traffic to their homepage around the time that piece went live and began gaining links.

See that next bump in March 2020?
A very successful post about coronavirus signage went live then. In the below you can see a screenshot below of the burst of links right after March 2020 that coincides with the boost in the overall traffic:

These may not be the only cause behind the spike in traffic during those timeframes, but they play a part.
A Mix of Metrics
As you can tell, it’s virtually impossible to give a 1-to-1 attribution in this fashion.
Your money page or homepage traffic may increase based on numerous other factors, such as social or traditional PR.
Your digital PR campaigns can also increase brand awareness, increase interest in the brand, and send more traffic to your homepage.
So, this is where you start looking at directional gains rather than individual metrics.
For example, Hana Montgomery from ShoutBravo told me about her agency’s campaign for DiscoverCars.com, which is focused on the most sustainable vacation destinations worldwide.
They found that Rhodes, Greece, is one of the top destinations. After the post started gaining coverage, the mayor of Rhodes, Mr. Antonis Kambourakis, heard about it and posted about it on his social media.

That has an impact on a site outside of just links. You can then watch the increase in direct traffic, social traffic, email signups, etc.
Sure, you can have a KPI of links per campaign, but connecting the dots to sitewide rankings becomes more difficult.
This makes sense because digital PR (and other tactics) should be part of the marketing mix, not your entire strategy.
Do You Want Homepage Links or Links to Content?
From an SEO perspective, if the content targets a keyword, get a link to the content.
If your brand isn’t well known or growing, getting links to your homepage may be more beneficial to establish some authority and awareness in the space.
But, for an established brand, linking to a blog might make more sense, though I’ve seen it go both ways.
Either way, if you are getting links to a homepage, ensure that it is optimized to pass value to your priority pages by linking to them prominently on the page.
What to Think About in the Pitch Process
Digital PR doesn’t end with a great piece of content. The pitch process is just as crucial to supporting your SEO goals.
Here are a few tips for ensuring your pitch gets you the best value.
1. Pitch to Quality, Relevant Sites
When building your target list, getting links from relevant sites is critical.
Google’s leaked documentation may show that links from highly clicked sections are worth more than those from low clicked sections.
Since most cannot access a website’s click data, you can lean on relevance and homepage.
Most sites highlight their homepage’s most important/relevant sections.
For instance, a site like Timeout, based on its homepage, mainly focuses on travel. You see it in the tagline.

And it’s one of the only categories they highlight on the homepage:

So, getting a link from them about a travel study would most likely hold more weight in Google’s eyes.
2. Pitch to Sites That Get Updated Frequently
The documentation also shows evidence that Google considers links from frequently updated sites.

What this primarily points to is news sites, aka digital PR.
3. Pitch to Sites That Provide Follow Links
Although new evidence shows that Google tracks unlinked and nofollow links, the most direct value is from followed, linked mentions.
So, to get the most SEO value out of a campaign, we should focus only on sites that provide follow-links.
You can easily tell if a link is a follow link using an SEO extension like Nofollow.
I cover this extensively in my post about building a media list from scratch.
4. Push Your Brand Keywords in Your Pitch
Anchor text and the surrounding text are essential for SEO. (Again, the new leaked documentation supports this.)
So, you want to ensure that your brand name is mentioned correctly.
Since many journalists copy exactly from a pitch, you can nudge them in the right direction by providing your brand name and a short description they will likely include in the article.
For example, if I were pitching a study to a journalist from our site, I’d say “a study by email outreach tool, BuzzStream.”
If you’re interested in learning more, we have some comprehensive articles on writing media pitches and email outreach templates.
5. Follow Up to Ask for a Link
Sometimes, journalists link incorrectly. They may forget to link, link to the wrong page, or sometimes even use a click-tracking link instead of your link.
Although journalists are incredibly busy, if your goal is to support SEO, it is always in your best interest to follow up and ask them to change the link.
The email draft would look something like this:
Hi [First Name],Thanks so much for mentioning [Your Brand/Site] in your [Research Page Title] post.
Would it be possible to add a link our [homepage/post]?
We think it would help give extra context for your readers and would help us out a lot.
Please let me know!
—
I wrote a whole guide about finding and claiming your unlinked mentions.
6. Maintain SEO Best Practices Sitewide
This might be obvious, but if your site doesn’t follow SEO best practices, you are hindering your digital PR performance.
You may get links, but to effectively support your core keywords or domain authority, you don’t want something like site speed or keyword cannibalization slowing you down.
SEO Doesn’t Equal Leads
To wrap up here, it’s worth mentioning that good SEO doesn’t always mean you are converting customers, generating leads, or turning a profit with a website.
SEO can support organic and some branding goals, but you need to consider the entire funnel for a customer.
Digital PR can be wielded for bottom-funnel keywords, but it is limited.
Think of digital PR as a supporting player in the entire marketing mix. You can integrate it into conversion goals, but if that’s the only thing you are leaning on for leads, you may be limited in what you can accomplish.

End-to-end outreach workflow
Check out the BuzzStream Podcast
